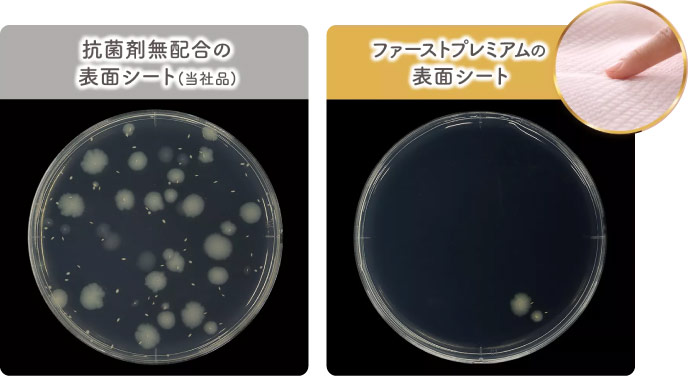

メリーズ ファーストプレミアム Sサイズ 54枚入り
20名様

"繊細な肌に5ッ星のやさしさを*"
新しいファーストプレミアムの約束です。
∗メリーズ内において

いつまでも触れていたくなるような、上質な肌ざわり。
肌に触れるシートには、オーガニック高純度のアルガンオイル使用。
※1 外装部分当社品比
JIS(L 1902:2015)の試験結果をもとにしたイメージ画像
※2 肌表面を抗菌するものではありません。
全ての細菌の増殖を抑制するものではありません。
赤ちゃんのさらさら肌が続きます。

おむつ全面でムレを追い出します。
※3 テープフック部を除く

独自の凹凸シートで、ゆるうんちも広げずキャッチ。
肌につきにくい。
朝まで長時間吸収。角まるテープで肌にやさしい
何度でもテープで留めやすい。

のび~るギャザーで背中ぴったりフィット。背中モレ安心。
※S,Mサイズのみ

緑色のギャザーが見えたら足まわりフィットのOKサイン!

※掲載内容はメーカー公式サイトより引用あり
上質な厳選素材で肌触りが抜群によい、メリーズ ファーストプレミアムの紙おむつ。おむつの吸収面が抗菌されていて、安心です。
フレフレママ!企画運営スタッフ Y.M